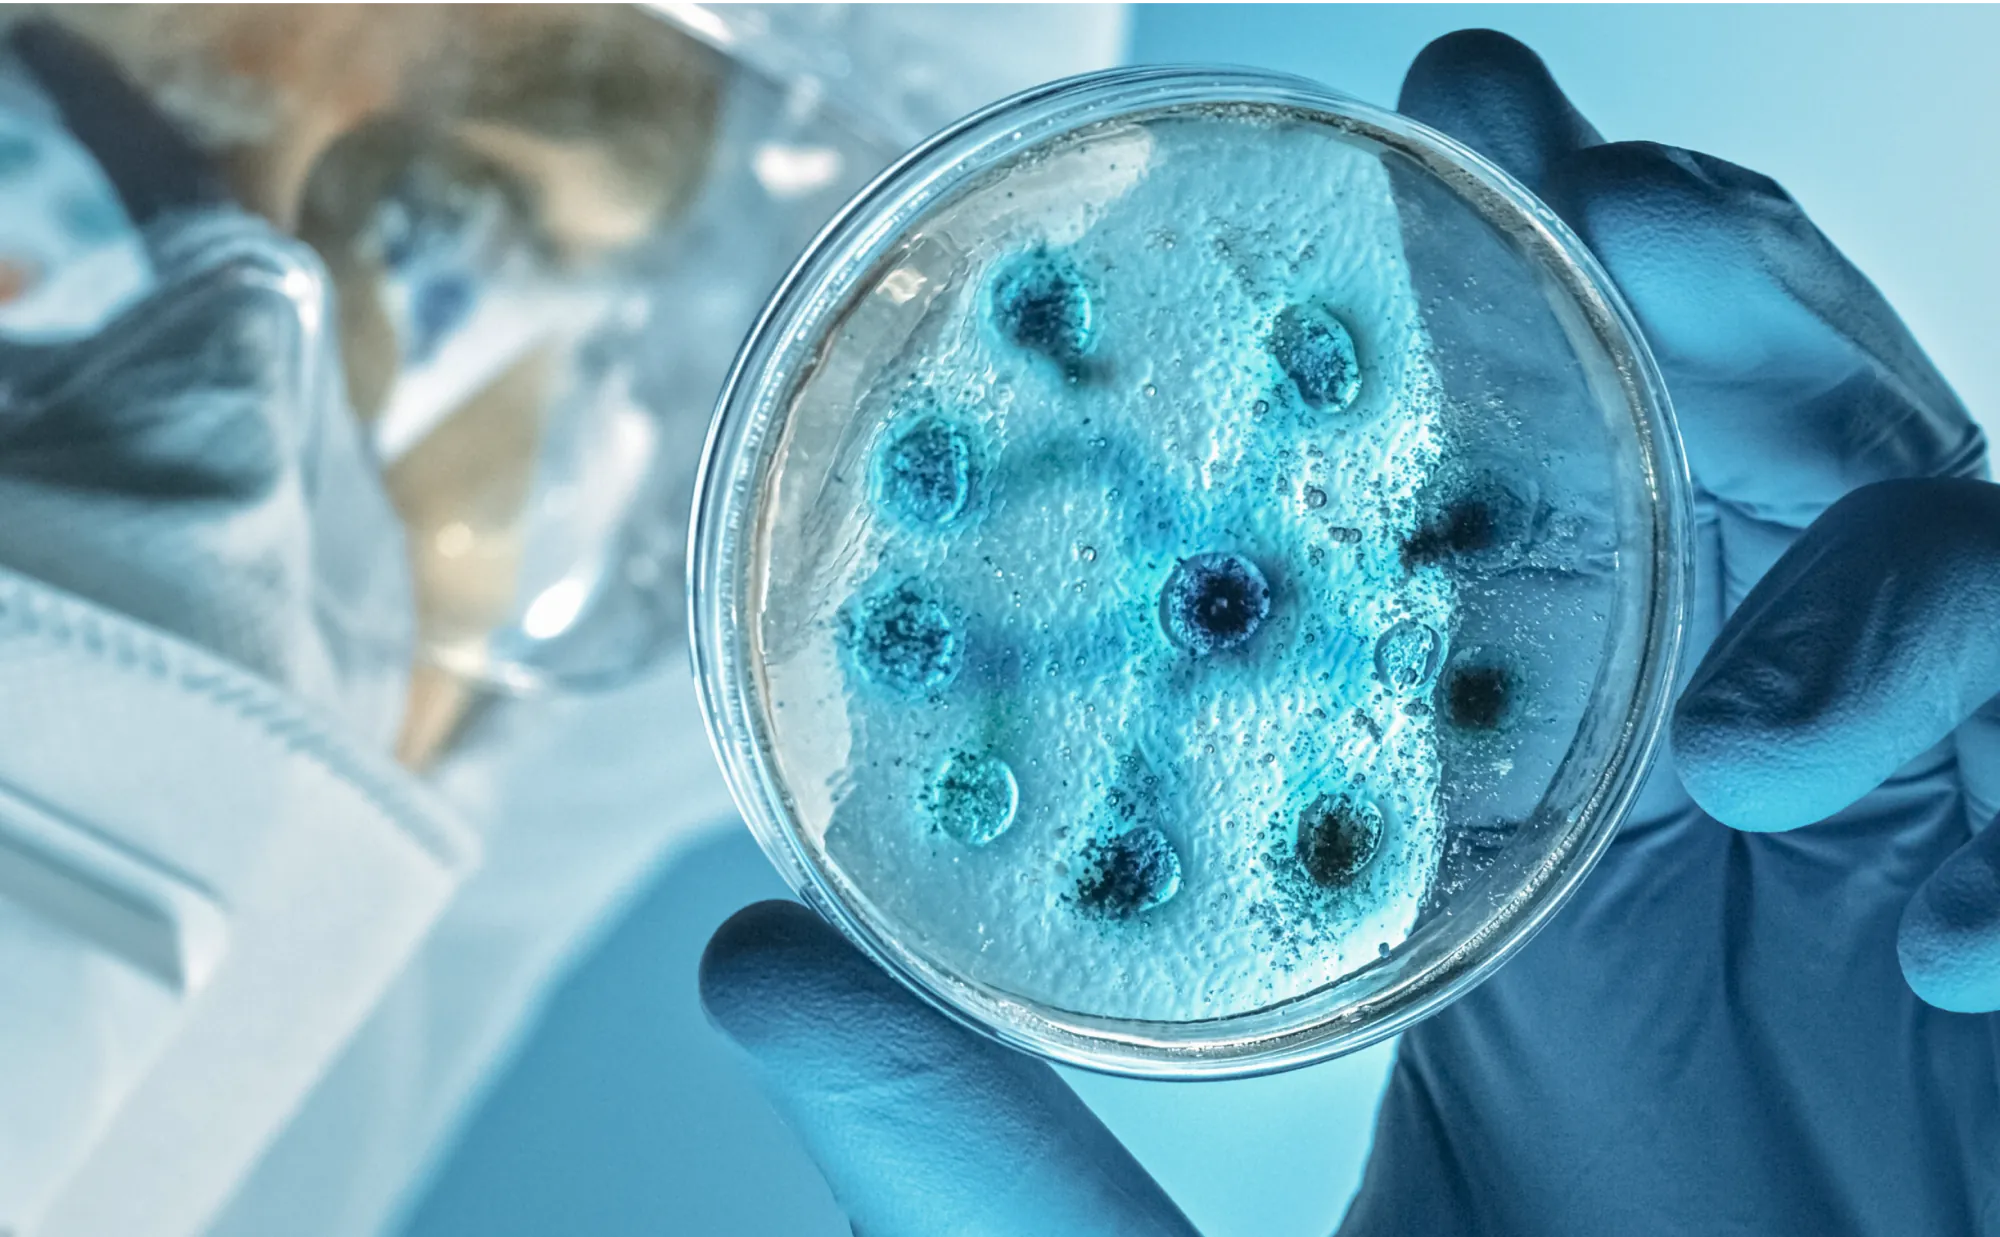

3 Liver-Toxic Foods You Must Avoid

Promotes Hyperinflammation and Makes Your Liver Work Overtime
The first liver-toxic food is sugar. Think of your liver as a factory responsible for processing everything you eat and drink.
Now, when you flood your system with too much sugar, especially fructose, it's like throwing a wrench in the works.
Your liver has to work overtime to deal with it, producing fats, uric acid, and free radicals. That’s right, when your liver processes sugar, it turns it into FAT.
👉🏽 Eating too much sugar doesn't just mess with your liver, it also reduces the effectiveness of insulin.
This can lead to type 2 diabetes and dumps even more fat onto your liver's workload. And to top it all off, sugar creates inflammation, damaging liver cells, even further accelerating the damage.
In a minute, I’ll show you how you can supercharge your liver function so that you don’t have to give up sweets altogether.

One Step Away From Embalming Fluid
The next liver-toxic substance is one you probably already know about – alcohol. When your liver breaks down alcohol, it creates nasty chemicals like acetaldehyde.
Guess what. Acetaldehyde is one chemical bond away from formaldehyde – which is embalming fluid. Heavy drinkers are literally embalming themselves alive.
👉🏽 At this stage your liver not only begins to become clogged with fat, it loses its function leading to something called alcoholic fatty liver.
When this happens fat accumulation goes into overdrive and the belly starts to bulge and protrude, which we playfully call 'beer belly' but trust me, there's nothing playful about it. It's the result of swollen, inflamed intestines pushing out, intertwined with thick white visceral fat.

Sinister Fats That Liquify Your Liver Cells
So, let's talk about trans fats, the kinds found in fried foods like french fries, donuts, in margarine, and shortening.
Trans fats are vegetable oils that have been processed using hydrogen gas and metals like aluminum, nickel or platinum which makes them solid at room temperature.
Trans fats also include oils that have been damaged by high heat, for example deep frying.
👉🏽 Trans fats are one molecule away from plastic, and are linked to heart disease and cancer. Trans fats also destroy and liquefy your liver cells, causing liver enzymes to leak into the bloodstream.
Understandably, this destroys your liver's function, causing an accumulation of fat in the bloodstream, which not only clogs arteries but also deposits fat all around the body.
So let's break it down and take a deeper look so that you understand precisely what happens inside the liver when you consume one of these three liver killers.
This will also help you understand how the breakdown can be halted and why changing one simple thing in your morning ritual could reverse years or even decades of damage.